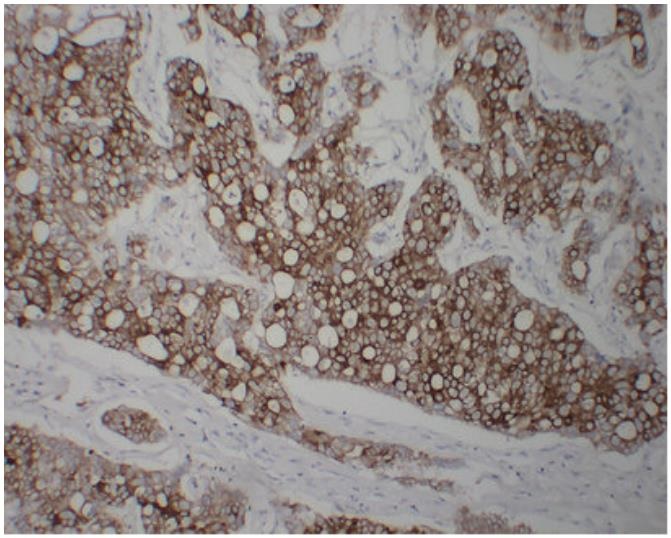

Factor XIIIa rabbit mAb(ABT77R)
Catalog NO.:YM6789
Applications :
Reactivity :
| 货号 | 规格 | 品牌 | 库存 | 价格 | 数量 | 操作 |
|---|---|---|---|---|---|---|
| YM6789-100ul | 100ul | EASYBIO |
|
|||
| YM6789-10ul | 10ul | EASYBIO |
|
Estrogen Receptor β mouse mAb(PT0318)
Catalog NO.:YM4163
Applications :
Reactivity :
| 货号 | 规格 | 品牌 | 库存 | 价格 | 数量 | 操作 |
|---|---|---|---|---|---|---|
| YM4163-100ul | 100ul | EASYBIO |
|
|||
| YM4163-10ul | 10ul | EASYBIO |
|
ERCC1 mouse mAb(PT0756)
Catalog NO.:YM4081
Applications :
Reactivity :
| 货号 | 规格 | 品牌 | 库存 | 价格 | 数量 | 操作 |
|---|---|---|---|---|---|---|
| YM4081-100ul | 100ul | EASYBIO |
|
|||
| YM4081-10ul | 10ul | EASYBIO |
|
Epithelial Membrane Antigen(MUC1) rabbit mAb(ABT48R)
Catalog NO.:YM6793
Applications :
Reactivity :
| 货号 | 规格 | 品牌 | 库存 | 价格 | 数量 | 操作 |
|---|---|---|---|---|---|---|
| YM6793-100ul | 100ul | EASYBIO |
|
|||
| YM6793-10ul | 10ul | EASYBIO |
|
E-Cadherin (ABT-CDHE) mouse mAb
Catalog NO.:YM6557
Applications :
Reactivity :
| 货号 | 规格 | 品牌 | 库存 | 价格 | 数量 | 操作 |
|---|---|---|---|---|---|---|
| YM6557-100ul | 100ul | EASYBIO |
|
|||
| YM6557-10ul | 10ul | EASYBIO |
|
Cytokeratin Pan mouse mAb(ABT-CKP)
Catalog NO.:YM6699
Applications :
Reactivity :
| 货号 | 规格 | 品牌 | 库存 | 价格 | 数量 | 操作 |
|---|---|---|---|---|---|---|
| YM6699-100ul | 100ul | EASYBIO |
|
|||
| YM6699-10ul | 10ul | EASYBIO |
|
Cytokeratin 8 (CK8) rabbit mAb(ABT170R)
Catalog NO.:YM6769
Applications :
Reactivity :
| 货号 | 规格 | 品牌 | 库存 | 价格 | 数量 | 操作 |
|---|---|---|---|---|---|---|
| YM6769-100ul | 100ul | EASYBIO |
|
|||
| YM6769-10ul | 10ul | EASYBIO |
|
Cytokeratin 8 (ABT-CK8) mouse mAb
Catalog NO.:YM6170
Applications :
Reactivity :
| 货号 | 规格 | 品牌 | 库存 | 价格 | 数量 | 操作 |
|---|---|---|---|---|---|---|
| YM6170-100ul | 100ul | EASYBIO |
|
|||
| YM6170-10ul | 10ul | EASYBIO |
|
Cytokeratin 6 (ABT-CK6) mouse mAb
Catalog NO.:YM6168
Applications :
Reactivity :
| 货号 | 规格 | 品牌 | 库存 | 价格 | 数量 | 操作 |
|---|---|---|---|---|---|---|
| YM6168-100ul | 100ul | EASYBIO |
|
|||
| YM6168-10ul | 10ul | EASYBIO |
|
Cytokeratin 5 (CK5) rabbit mAb(ABT168R)
Catalog NO.:YM6796
Applications :
Reactivity :
| 货号 | 规格 | 品牌 | 库存 | 价格 | 数量 | 操作 |
|---|---|---|---|---|---|---|
| YM6796-100ul | 100ul | EASYBIO |
|
|||
| YM6796-10ul | 10ul | EASYBIO |
|
Cytokeratin 20 (CK20) rabbit mAb(ABT24R)
Catalog NO.:YM6783
Applications :
Reactivity :
| 货号 | 规格 | 品牌 | 库存 | 价格 | 数量 | 操作 |
|---|---|---|---|---|---|---|
| YM6783-100ul | 100ul | EASYBIO |
|
|||
| YM6783-10ul | 10ul | EASYBIO |
|
Cytokeratin 19 (CK19) rabbit mAb(ABT166R)
Catalog NO.:YM6776
Applications :
Reactivity :
| 货号 | 规格 | 品牌 | 库存 | 价格 | 数量 | 操作 |
|---|---|---|---|---|---|---|
| YM6776-100ul | 100ul | EASYBIO |
|
|||
| YM6776-10ul | 10ul | EASYBIO |
|
Cytokeratin 19 (ABT-CK19) mouse mAb
Catalog NO.:YM6577
Applications :
Reactivity :
| 货号 | 规格 | 品牌 | 库存 | 价格 | 数量 | 操作 |
|---|---|---|---|---|---|---|
| YM6577-100ul | 100ul | EASYBIO |
|
|||
| YM6577-10ul | 10ul | EASYBIO |
|
Cytokeratin 18 rabbit mAb(ABT165R)
Catalog NO.:YM6792
Applications :
Reactivity :
| 货号 | 规格 | 品牌 | 库存 | 价格 | 数量 | 操作 |
|---|---|---|---|---|---|---|
| YM6792-100ul | 100ul | EASYBIO |
|
|||
| YM6792-10ul | 10ul | EASYBIO |
|
Cytokeratin 18 (PT1876) mouse mAb
Catalog NO.:YM6625
Applications :
Reactivity :
| 货号 | 规格 | 品牌 | 库存 | 价格 | 数量 | 操作 |
|---|---|---|---|---|---|---|
| YM6625-100ul | 100ul | EASYBIO |
|
|||
| YM6625-10ul | 10ul | EASYBIO |
|
Cytokeratin 17 (CK17) rabbit mAb(ABT164R)
Catalog NO.:YM6768
Applications :
Reactivity :
| 货号 | 规格 | 品牌 | 库存 | 价格 | 数量 | 操作 |
|---|---|---|---|---|---|---|
| YM6768-100ul | 100ul | EASYBIO |
|
|||
| YM6768-10ul | 10ul | EASYBIO |
|
Cytokeratin 17 (ABT-CK17) mouse mAb
Catalog NO.:YM6165
Applications :
Reactivity :
| 货号 | 规格 | 品牌 | 库存 | 价格 | 数量 | 操作 |
|---|---|---|---|---|---|---|
| YM6165-100ul | 100ul | EASYBIO |
|
|||
| YM6165-10ul | 10ul | EASYBIO |
|
Cytokeratin 15 (CK15) rabbit mAb(ABT162R)
Catalog NO.:YM6772
Applications :
Reactivity :
| 货号 | 规格 | 品牌 | 库存 | 价格 | 数量 | 操作 |
|---|---|---|---|---|---|---|
| YM6772-100ul | 100ul | EASYBIO |
|
|||
| YM6772-10ul | 10ul | EASYBIO |
|
Cytokeratin 14 (ABT-CK14) mouse mAb
Catalog NO.:YM6164
Applications :
Reactivity :
| 货号 | 规格 | 品牌 | 库存 | 价格 | 数量 | 操作 |
|---|---|---|---|---|---|---|
| YM6164-100ul | 100ul | EASYBIO |
|
|||
| YM6164-10ul | 10ul | EASYBIO |
|
Cytokeratin 13 (ABT-CK13) mouse mAb
Catalog NO.:YM6163
Applications :
Reactivity :
| 货号 | 规格 | 品牌 | 库存 | 价格 | 数量 | 操作 |
|---|---|---|---|---|---|---|
| YM6163-100ul | 100ul | EASYBIO |
|
|||
| YM6163-10ul | 10ul | EASYBIO |
|